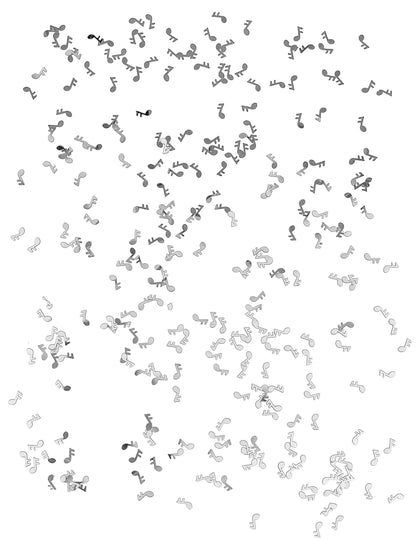

Becsült szabványos kézbesítés
10 Oct
Megrendelés elhelyezve
10 Oct - 13 Oct
Elküldött
16 Oct - 17 Oct
Kiszállított
Méret útmutató
Méret útmutató
Megtalálható a...
10 Oct
Megrendelés elhelyezve
10 Oct - 13 Oct
Elküldött
16 Oct - 17 Oct
Kiszállított
Megtalálható a...